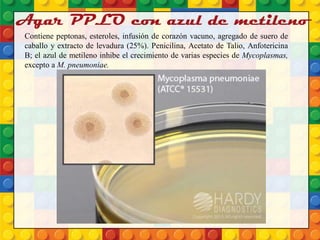
Agar PPLO con azul de metileno
Contiene peptonas, esteroles, infusión de corazón vacuno, agregado de suero de
caballo y extracto de levadura (25%). Penicilina, Acetato de Talio, Anfotericina
B; el azul de metileno inhibe el crecimiento de varias especies de Mycoplasmas,
excepto a M. pneumoniae.

El documento es una revisión histórica y técnica sobre los géneros Mycoplasma y Ureaplasma, destacando su taxonomía, características microbiológicas, patógenos relacionados y métodos de diagnóstico. Se enfatiza que Mycoplasma pneumoniae es el único causante de infecciones respiratorias en adultos, mientras que Ureaplasma urealyticum se asocia con infecciones del tracto genital. Se discuten también las limitaciones en el tratamiento debido a la resistencia a antibióticos beta-lactámicos por la ausencia de pared celular.